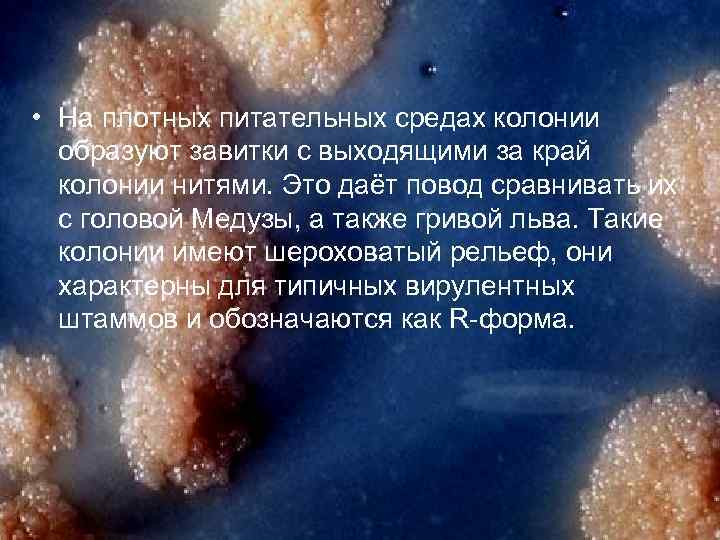
• На плотных питательных средах колонии образуют завитки с выходящими за край колонии

сибирская язва.ppt
- Количество слайдов: 32


• Возбудитель сибирской язвы – Bacillus anthracis. Этот микроб часто называют бациллой антракса(углевик) из-за черного налета, покрывающего эти язвы. Инфекционный процесс протекает преимущественно остро с явлениями септицимии или с образованием различной величины карбункулов.

Неподвижная, грамположительная (в молодых и старых культурах встречаются и грамотрицательные клетки), имеет три формы(вегетативную, споровую, капсульную), размером 1 -1, 3 х 3, 0 -10, 0 мкм. При температуре ниже 12 и выше 42 С, а также в живом организме или невскрытом трупе, в крови и сыворотке животных споры не образуются.

Ø по способу дыхания относят к факультативным анаэробам (хорошо растёт в аэробных и анаэробных условиях), хорошо растет на универсальных средах (МПБ, МПА, МПЖ, картофеле, молоке). Оптимальная температура роста на МПА 35 -37 o. С, в бульоне 32 -33 o. С. При температуре ниже 12 и выше 45 o. С не растет. Оптимум р. Н сред 7, 27, 6.

• На питательных средах возбудитель сибирской язвы образуют более длинные цепочки; при этом морфология палочек несколько изменяется — они слегка утолщены на концах и образуют сочленения, напоминающие «бамбуковую трость» . Эти морфологические изменения ещё более явно проявляются при температурной фиксации при окрашивании.
• На плотных питательных средах колонии образуют завитки с выходящими за край колонии нитями. Это даёт повод сравнивать их с головой Медузы, а также гривой льва. Такие колонии имеют шероховатый рельеф, они характерны для типичных вирулентных штаммов и обозначаются как R-форма.

u Ферменты : липаза, протеаза, желатиназа, дегидраза, пероксидаза, каталаза, и др. Ферментирует с образованием кислоты без газа глюкозу, мальтозу, сахарозу, трегалозу, фруктозу и декстрин. На средах с глицерином и салицином возможно слабое кислотообразование.

u Арабинозу, рамнозу, галактозу, маннозу, раффинозу, инулин, маннит, дульцит, сорбит, инозит не сбраживает. . u Утилизирует цитраты, образует ацетилметилкарбинол (реакция Фогеса Проскауэра положительная). Выделяет аммиак. Редуцирует метиленовый синий и восстанавливает нитраты в нитриты. Некоторые штаммы образуют сероводород

§ образует сложный экзотоксин, состоящий из трех компонентов или факторов I, III. I фактор вызывает местную воспалительную реакцию - отек и разрушение тканей. II фактор - носитель защитных свойств, обладает выраженным иммуногенным действием. III фактор в смеси со протективным вызывает гибель крыс, белых мышей и морских свинок. Каждый из трех факторов обладает выраженной антигенной функцией и серологически

n В состав антигенов входят неиммуногенный соматический полисахаридный комплекс и капсульный глутаминполипептид. Полисахаридный антиген не создает иммунитета у животных и не определяет агрессивных функций микроорганизма.

Ø В невскрытом трупе вегетативная клетка микроба разрушается в течение 2 -3 сут, в зарытых трупах сохранятся до 4 дней. В замороженном мясе при минус 15 o. С жизнеспособна 15 дней. В навозная жиже, смешанной с сибиреязвенной кровью, погибает через 2 -3 ч, споры же остаются в ней вирулентными в течение месяцев. В почве более 50 лет. Спирт, эфир, 2 %-ный формалин, 5 %-ный фенол, 5 -10 %-ный хлорамин, свежий 5 %-ный раствор хлорной извести, перекись водорода разрушают вегетативные клетки в течение 5 мин. , 3%-ный раствор перекиси водорода - через 1 ч.

Ø Вегетативные клетки при нагревании до 5055 o. С гибнут в течение 1 ч, при 75 o. С - через 1 мин, при кипячении - мгновенно. При медленном высушивании наступает спорообразование и микроб не гибнет. При минус 10 o. С бактерии сохраняются 24 дня, при минус 24 o. С - 12 дней. Воздействие прямого солнечного света обезвреживает бактерии через несколько минут. Кипячение - через 1 ч. Возбудитель сибирской язвы проявляет высокую чувствительность к пенициллину, хлортетрациклину и левомицетину, а также к лизоциму. Бактериостатическим эффектом на протяжении 24 ч обладает свежевыдоенное молоко коров.

Ø К возбудителю сибирской язвы восприимчивы все виды млекопитающих. Чаще болеют овцы, крупный рогатый скот, лошади, козы, буйволы, верблюды и северные олени, могут заражаться ослы и мулы. Свиньи менее чувствительны. Среди диких животных восприимчивы все травоядные. Известны случаи заболевания собак, волков, лисиц, песцов, среди птиц - уток и страусов.

Ø 1. 2. 3. У человека выделяют три формы патогенности: кожная - смертность 20% легочная – смертность 100% кишечная – смертность 100%

У животных выделяют две формы болезни: 1. Кишечная 2. Кожная Ø

Ø Заражение животных происходит преимущественно алиментарно. Через поврежденную слизистую пищеварительного тракта микроб проникает в лимфатическую систему, а затем в кровь, где фагоцитируется и разносится по всему организму, фиксируясь в элементах лимфоидно-макрофагальной системы, после чего снова мигрирует в кровь, обусловливая септицемию.

Ø Экзотоксин разрушает фагоциты, поражает центральную нервную систему, вызывает отек, возникает гипергликемия. В терминальной фазе процесса в крови снижается содержание кислорода до уровня, несовместимого с жизнью.

Ø Нельзя исключить аэрогенное заражение животных (особенно овец) при вдыхании пыли, содержащей споры возбудителя. Возможен и трансмиссивный путь заражения при обилии кровососущих насекомых (слепни, мухи-жигалки, комары). Доказано, что слепни, например, могут воспринять возбудителя сибирской язвы не только от больных животных, но и от трупов, из инфицированных водоемов, из почвы.

1. Прижизненный: а) продовольственное сырье б) объекты окружающей среды - почва, трава, фураж, подстилка, вода и т. д. 2. Трупный материал - кровь, экссудаты, кусочки органов (селезенки, печени, лимфоузлов и др. );

При подозрении на сибирскую язву категорически запрещается вскрывать трупы павших животных. Для исследования чаще всего направляют ухо павшего животного или мазок крови. Материал должен быть свежим.





Ø Бактериоскопия. Из патологического материала для микроскопии готовят мазки, часть красят по Граму и обязательно на капсулы по Михину и Ольту. Важным диагностическим признаком является обнаружение типичных по морфологии капсульных палочек.

Ø Посев на питательные среды. Исходный материал засевают в МПБ и на МПА (р. Н 7, 2 -7, 6), инкубируют посевы при температуре 37 С в течение 18 -24 ч, при отсутствии роста их выдерживают в термостате еще 2 сут. В мазках из культур обнаруживают бескапсульные палочки и споры.

Ø Биологическая проба. Осуществляется на грызунах, одновременно с посевом материала на питательные среды. Мыши погибают через 1 -2 сут, морские свинки и кролики - через 2 -4 сут. Павших животных вскрывают, делают мазки и посевы из крови сердца, селезенки, печени и инфильтрата на месте инъекции исследуемого материала. Идентификация. Возбудителя сибирской язвы следует дифференцировать от сапрофитных бацилл: B. cereus, B. megaterium, B. mycoides и B. subtilis

Признаки Подвижность B. B. B. anthracis cerius megateri mycoides subtilis um + + Капсулообразов ание + - - Гемолиз(на кров. Агаре) - + - + Чувст. к пеницилину + - - Чувст. к сибиреяз. фагу + - - Р-ция с люминисцир сывороткой + - - Пат. для белыж мышей + + - -

Серологическое исследование. Для обнаружения сибиреязвенных антигенов при исследовании кожевенного и мехового сырья, загнившего патологического материала, а также свежего патологического материала и серологической идентификации выделенных культур применяют реакцию преципитации по Асколи.

Аллергическая проба состоит во внутрикожном введении 0, 1 мл антраксина - антигена, извлекаемого из оболочки сибиреязвенного возбудителя. На месте введения у больных и переболевших сибирской язвой появляются гиперемия и инфильтрат размером 3, 5 х 3 см.

Формирование иммунитета инфекции по типу антитоксического обуславливает протективный антиген. В результате естественного заражения и переболевания сибирской язвы у животных возникает длительный иммунитет. С целью активной защита животных от сибирской язвы применяют живые споровые сибиреязвенные вакцины. Для лечения и пассивной профилактики применяют противосибиреязвенную сыворотку и глобулин. Иммунитет наступает через несколько часов и сохраняется до 14 дней.

сибирская язва.ppt